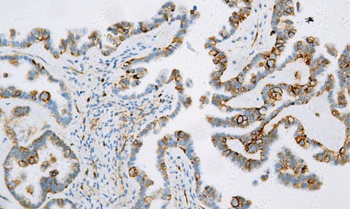
CD99

You have no items in your shopping cart.
Search results for: 'CD99'
- CD99 Antibody [orb1553811]
ELISA, IHC-P, WB
Human, Mouse
Rabbit
Polyclonal
Unconjugated
100 μl, 50 μl, 200 μl - CD99 monoclonal antibody [orb1724403]
IHC-P, IP, WB
Human, Mouse
Rabbit
Monoclonal
Unconjugated
100 μl, 50 μl - CD99 monoclonal antibody [orb1723152]
ICC, IHC-Fr, IHC-P, IP, WB
Human
Rabbit
Monoclonal
Unconjugated
100 μl, 50 μl